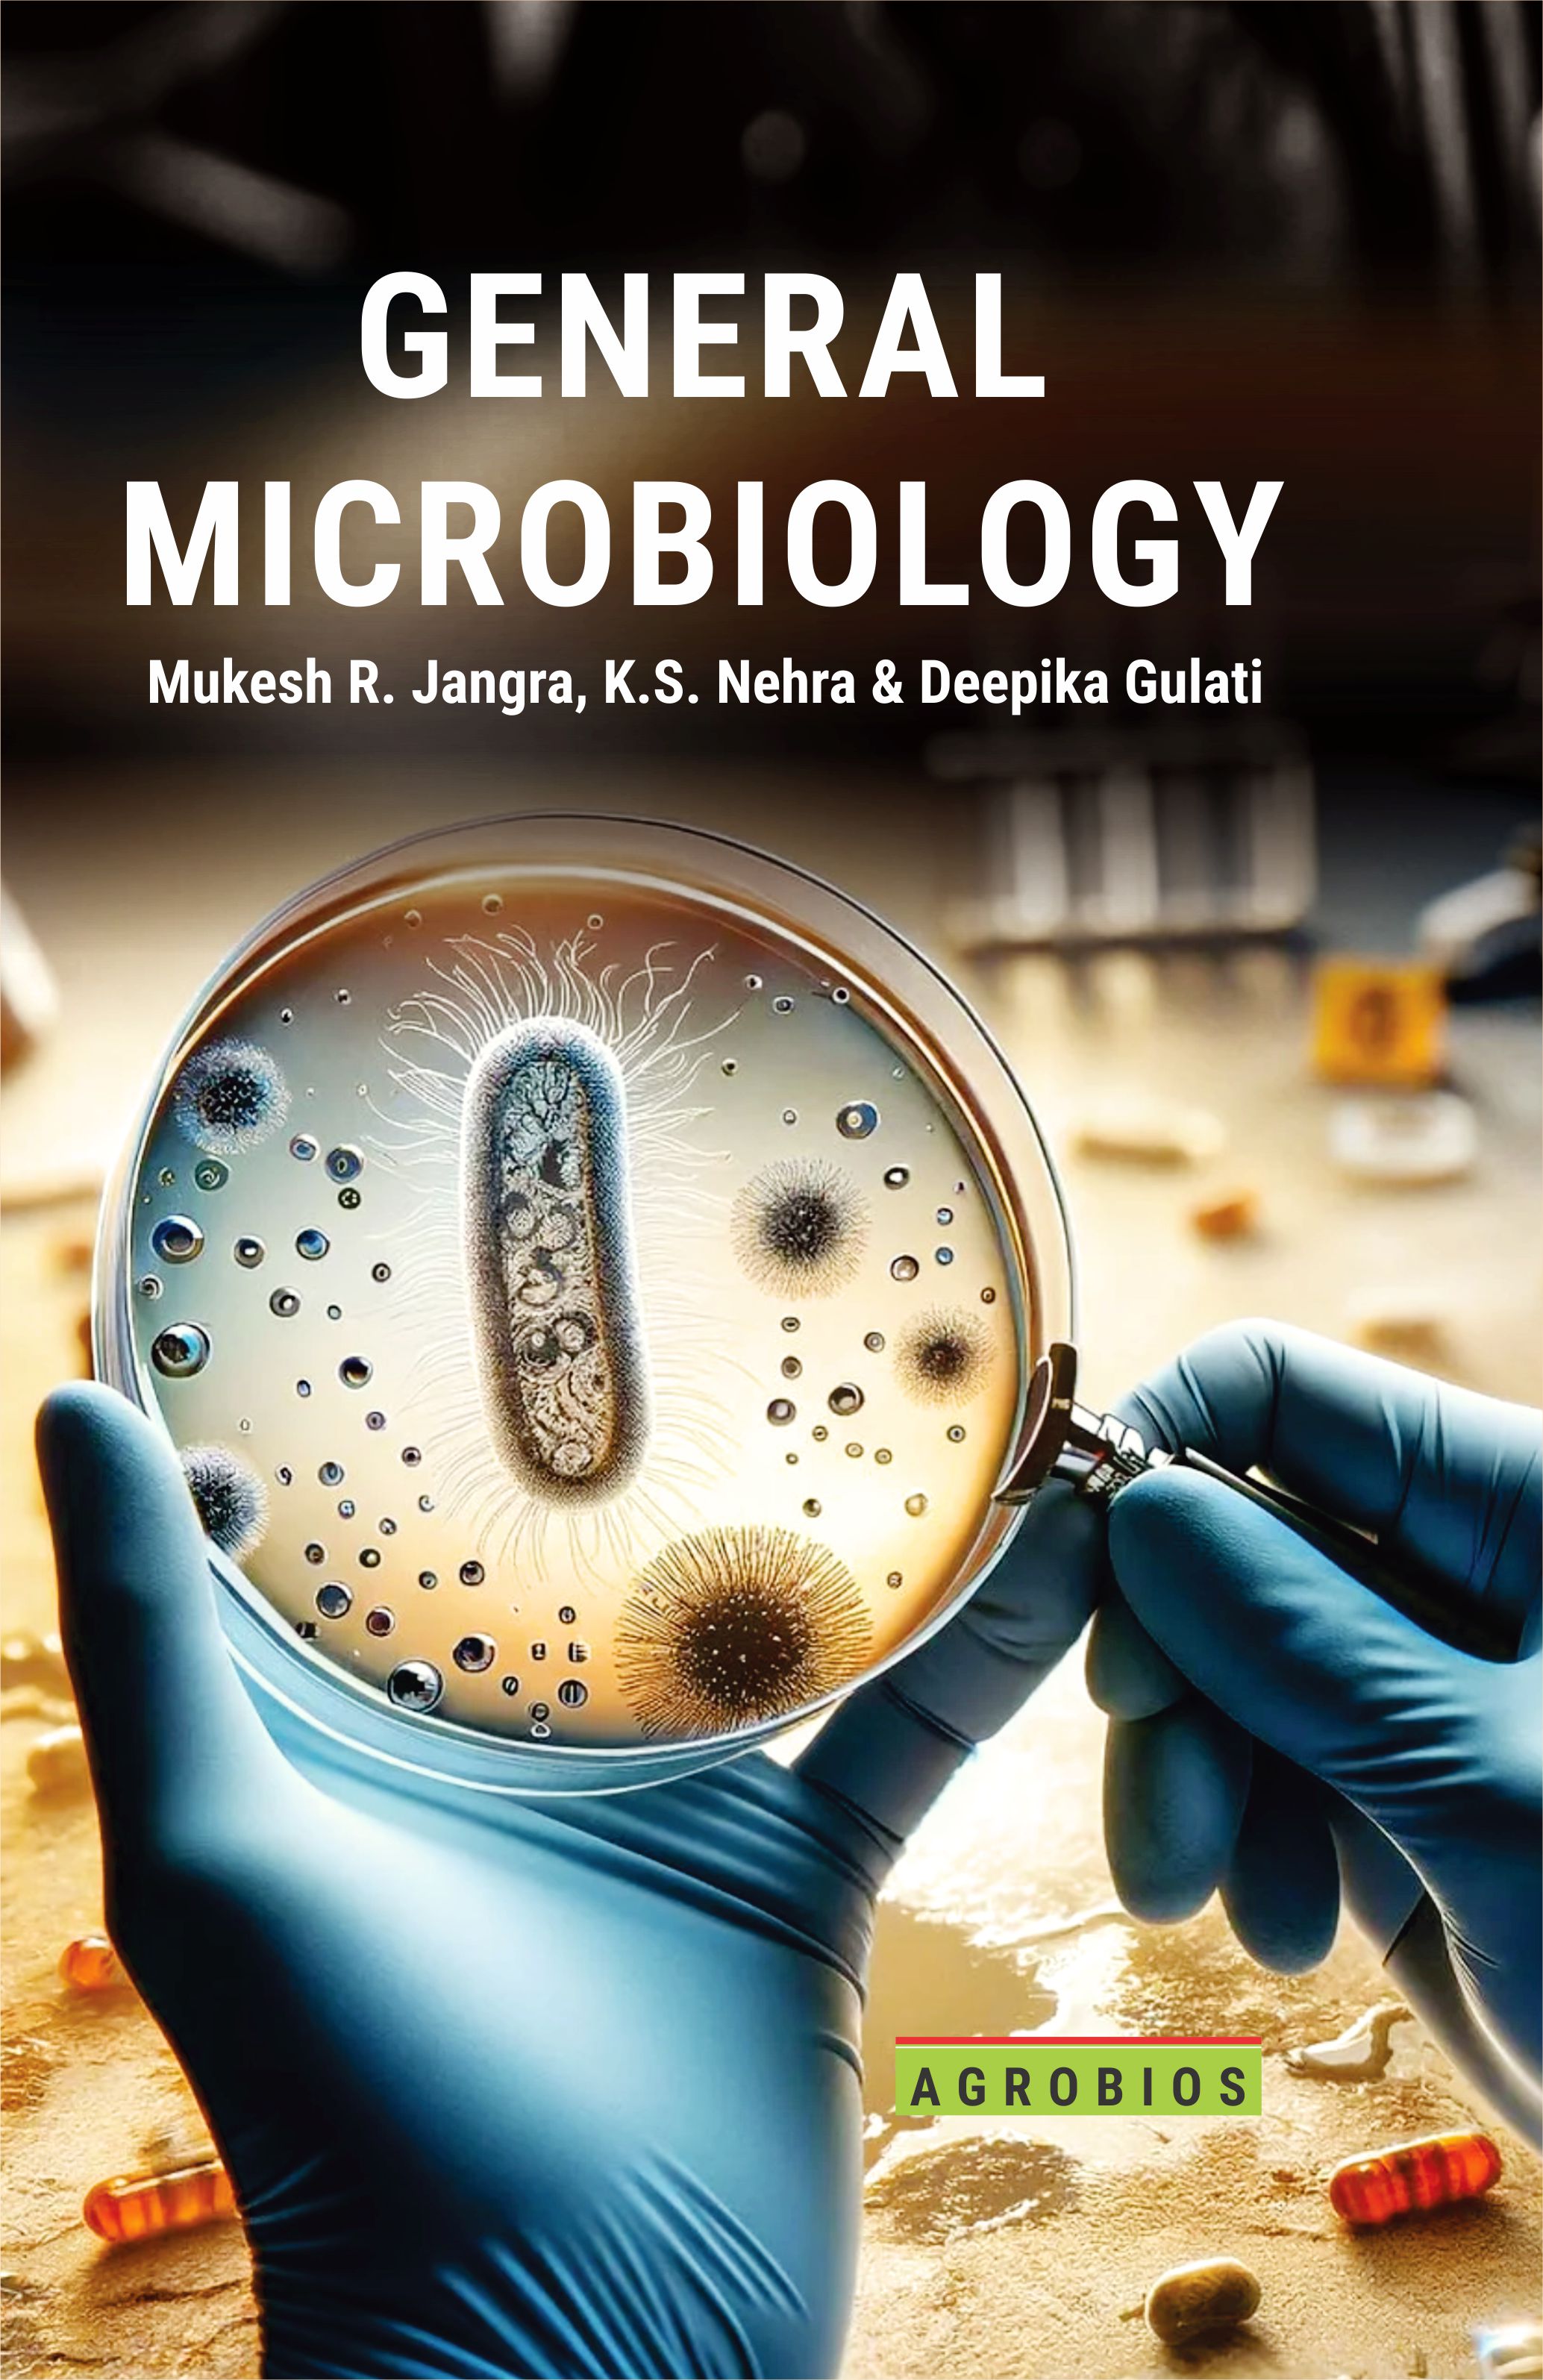
General Microbiology

A Textbook Of Basic Biotechnology NEW
Dr. Deepika Gulati
 555
555
Table of Contents..
Book Details
Book Title:
A Textbook Of Basic Biotechnology NEW
A Textbook Of Basic Biotechnology NEW
Book Type:
TEXT-CUM-REFERENCES BOOK
TEXT-CUM-REFERENCES BOOK
No Of Pages:
120
120
Color Pages :
0
0
Color Pages :
0
0
Book Size:
DEMY (5.5X8.5)
DEMY (5.5X8.5)
Weight:
150 Gms
150 Gms
Copyright Holder:
All Right Reserved
All Right Reserved
Imprint:
M/s AGROBIOS (INDIA)
M/s AGROBIOS (INDIA)
Readership:
UG STUDENTS |
UG STUDENTS |